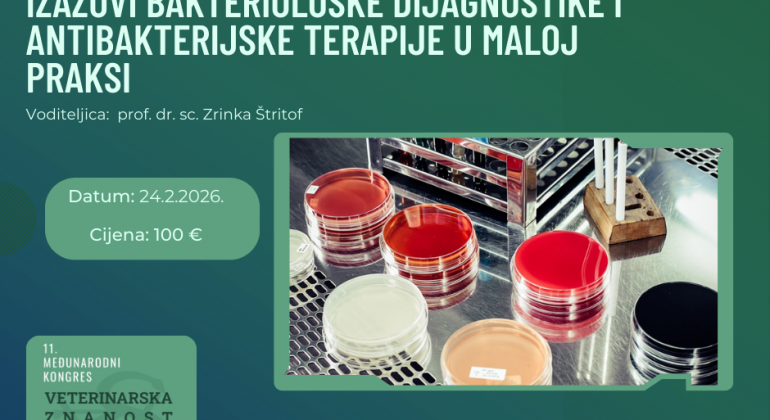
Izazovi bakteriološke dijagnostike i antibakterijske terapije u maloj praksi

Pridružite nam se na stručnoj dvostatnoj radionici namijenjenoj veterinarima koji žele sigurnije i racionalnije donositi odluke u liječenju bakterijskih infekcija.
U fokusu radionice:
- pravilno uzorkovanje i slanje kliničkih materijala
- najčešće pogreške u praksi i njihov utjecaj na dijagnostiku
- osnove bakteriološke obrade i tumačenje nalaza
- kada je sistemska antimikrobna terapija doista potrebna
- kako pravilno koristiti antibiogram u svakodnevnoj praksi.
Antimikrobna rezistencija sve je veći izazov – ova radionica pomaže povezati kvalitetnu dijagnostiku s odgovornom primjenom antibiotika kroz konkretne primjere i interaktivnu raspravu.
Idealno za veterinare koji žele unaprijediti praksu temeljenu na suvremenim smjernicama.
Radionica će se održati 24. veljače 2026. na Veterinarskom fakultetu Sveučilišta u Zagrebu, a voditeljica radionice je prof. dr. sc. Zrinka Štritof.
Više informacija o radionici i prijave pronađite na: https://veterinaryscienceprofession.eu/product/izazovi-bakterioloske-dijagnostike-i-antibakterijske-terapije-u-maloj-praksi/




